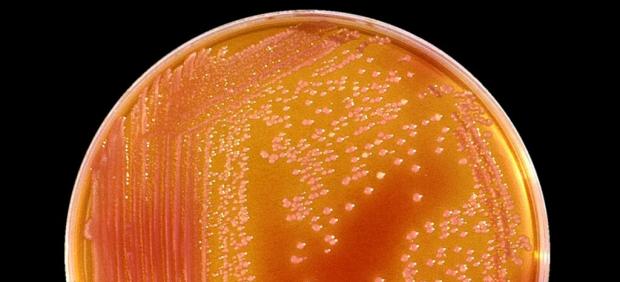
Bacteria Serratia

EFE
- Son los pacientes con patologías graves y con un bajo nivel de defensas los que son más vulnerables.
- Este tipo de gérmenes existe en todos lo hospitales como consecuencia de la utilización de antibióticos.
Dos bebés que se encuentran ingresados en la Unidad de Cuidados Intensivos (UCI) Neonatal del Hospital Materno Infantil Virgen de las Nieves de Granada se han visto afectados por serratia, una bacteria oportunista no multirresistente que responde bien al tratamiento antibiótico y que únicamente se contagia por contacto.
Según ha informado este jueves la dirección del centro hospitalario, los dos menores están siendo tratados con fármacos y se han adoptado las medidas oportunas de control y prevención establecidas para estos casos.
Han explicado que, como ocurre con el resto de bacterias, son los pacientes críticos con patologías graves de base y con un bajo nivel de defensas los que son más vulnerables ante estos microorganismos.
Una comisión de trabajo del hospital, en la que están presentes profesionales de diferentes disciplinas monitoriza la evolución de estos casos y se encarga de establecer las medidas necesarias para prevenir futuros casos.
Como medidas de prevención, se está llevando a cabo la limpieza y desinfección de la zona donde se detectaron los casos: el área de Cuidados Intensivos Neonatales.
Este tipo de gérmenes que se denominan oportunistas, como la serratia, la klebsiella o los estafilococos, existen en todos lo hospitales como consecuencia de la utilización de antibióticos y la manipulación intensiva (ventilación asistida, nutrición parenteral, canalización de vías centrales) de pacientes con mayor grado de vulnerabilidad que, como en este caso, requieren cuidados especiales por tratarse de recién nacidos prematuros. han añadido las fuentes.